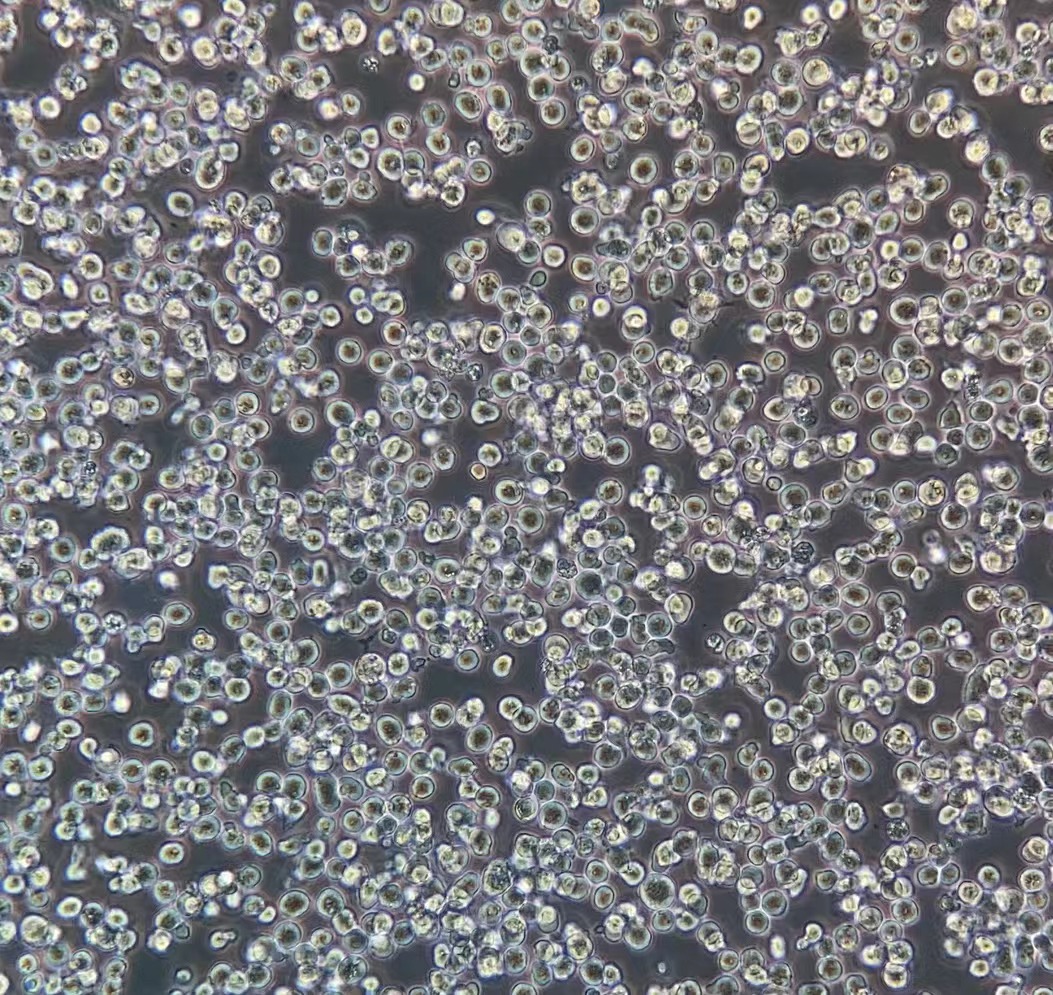

|
种属 |
小鼠 |
|
别称 |
EL-4; EL 4; E.L.4 |
|
组织来源 |
T淋巴细胞 |
|
疾病 |
淋巴瘤 ,小鼠白血病 |
|
传代比例/细胞消化 |
1:2传代 ,维持细胞密度在1*10^5-1*10^6cells/mL |
|
完全培养基配置 |
DMEM(含NaHCO3 1.5g/L)培养基;10%马血清;1%双抗 |
|
简介 |
EL4是从用9 ,10-二甲基-1 ,2-苯并蒽在C57BL小鼠中诱导的淋巴瘤中建立的。 能抗0.1 mM 氢化可的松 ,对20 mcg/ml PHA敏感。 还有一个亚株(EL4.IL-2 , ATCC TIB-181)可以生成高水平的IL-2。 检测表明肢骨发育畸形病毒 (鼠痘)阴性。 |
|
形态 |
淋巴母细胞样 |
|
生长特征 |
悬浮生长 |
|
倍增时间 |
每周 2 至 3 次 |
|
抗原表达 |
H-2b; Thy-1.2 |
|
培养条件 |
气相:空气 ,95% ;二氧化碳 ,5%。 温度:37摄氏度 ,培养箱湿度为70%-80%。 |
|
冻存条件 |
冻存液:90%FBS ,DMSO 10%, 或使用非程序冻存液:官网货号JY-H040 |
|
保藏机构 |
ATCC; TIB-39 |
|
备注 |
该细胞为悬浮细胞 ,请注意离心收集细胞悬液 ,请勿直接倒掉细胞培养液。 |
|
产品使用 |
仅限于科学研究 ,不可作为动物或人类疾病的治疗产品使用。 |